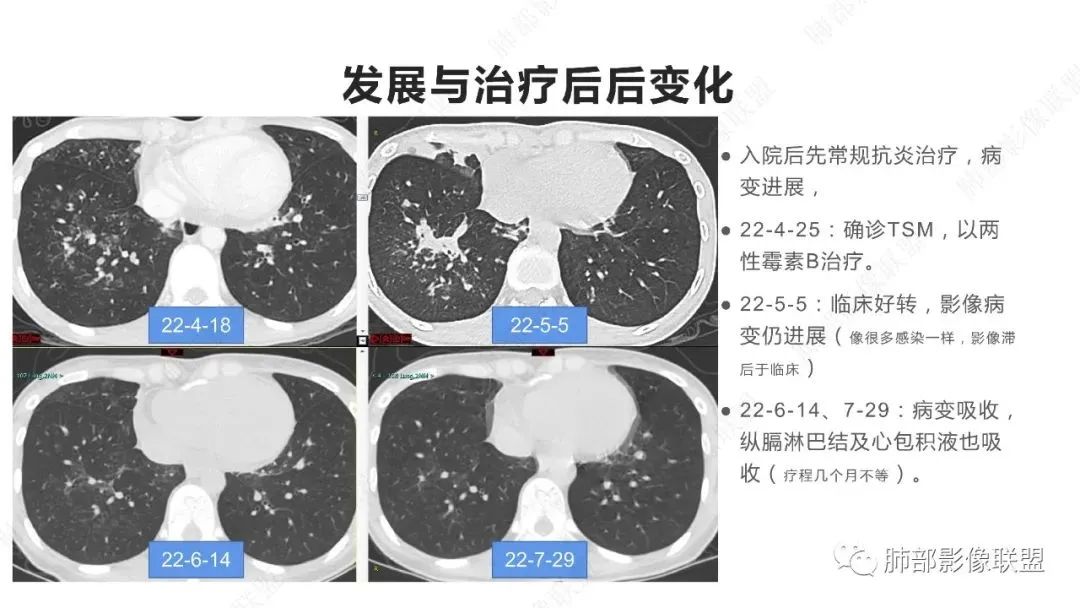
【PPT】马尔尼菲篮状菌的CT表现-4 【PPT】马尔尼菲篮状菌的CT表现-4

马尔尼菲篮状菌病(TSM) 是由马尔尼菲篮状菌感染引起的一种致死性深部真菌病,马尔尼菲篮状菌主要侵犯单核巨噬系统,可表现为局灶性和播散性感染,在免疫功能低下的感染者中,死亡率高。该菌是由Capponi1956年从越南野生中华竹鼠肝脏中首次分离出并命名。该病主要流行于东南亚一带,在我国以广西广东多见。有文献研究中国大陆1984年到2009年感染马尔尼菲篮状菌668例患者中有99.4%病例发生在中国南部,以广西广东为主,有87.7%病例发生在艾滋病患者中,有3.8%的病人发生在其它免疫抑制患者中,有8.5%发生在免疫功能正常者。
马尔尼菲篮状菌的传播途径尚不明确,公认的主要传播途径有呼吸道,消化道,外伤等,亦不除外接触孢子污染的土壤而感染。
马尔尼菲篮状菌病的常见的临床表现为发热,贫血,消瘦,呼吸道症状,皮肤损害,肝脾肿,淋巴结肿大。播散型TSM常累及肺,皮肤,网状内皮系统(包括骨,骨髓,关节,淋巴结,心包,肝脾)。不同宿主状态下TSM临床表现也有不同,HIV阳性患者主要表现为持续性发热,软疣状皮肤损害,血培养阳性率高,白细胞正常或偏低等。HIV阴性患者主要表现为间歇发热,皮下结节和脓肿,淋巴结肿大,骨痛溶骨,白细胞增高等。
马尔尼菲篮状菌的诊断主要靠沙氏琼脂培养基25℃及37℃环境下可培养出(金标准)。
马儿尼菲篮状菌肺部表现具有多样性,可以表现为实质改变、间质改变、纵隔淋巴结肿大、胸膜改变及气管改变。
有文献报道马尔尼菲篮状菌病患者82.7%胸部CT有异常改变,胸部CT表现:45.6%患者肺野斑片状浸润阴影或局限性肺实变,11.9%患者表现为结节影,11.5%患者表现为毛玻璃改变,8.4%患者表现为弥漫性粟粒样病变,5.3%患者表现为结节状肿块影。45.1%患者胸部影像学伴肺门或纵隔淋巴结肿大,23.5%患者伴胸腔积液,8.0%伴空洞病灶。
 纵隔大细胞神经内分泌癌1例CT影像
纵隔大细胞神经内分泌癌1例CT影像  张力性纵隔气肿影像表现及严重度分级
张力性纵隔气肿影像表现及严重度分级  迅速增大的肺部结节,首先考虑良性,确诊需要肺穿
迅速增大的肺部结节,首先考虑良性,确诊需要肺穿  肺隔离症:易误诊为肺癌的占位性病变,肺穿刺禁忌!
肺隔离症:易误诊为肺癌的占位性病变,肺穿刺禁忌!  肺段与肺内管道应用解剖
肺段与肺内管道应用解剖  肺转移瘤的十种不典型CT表现
肺转移瘤的十种不典型CT表现  肺内淋巴结的CT表现特点及与病理对照
肺内淋巴结的CT表现特点及与病理对照  肺实变与肺不张的CT鉴别诊断
肺实变与肺不张的CT鉴别诊断  医生现身说法,这五种忙帮不得!
医生现身说法,这五种忙帮不得!  北大教授:要真正让医务人员有阳光体面的收入!医
北大教授:要真正让医务人员有阳光体面的收入!医  为值夜班的医生护士鼓与呼:请给我们更多关注!
为值夜班的医生护士鼓与呼:请给我们更多关注!  广东拟取消医院用药数量限制,满足患者多样性需求
广东拟取消医院用药数量限制,满足患者多样性需求  博士、硕士入职就给精装房!又有医院不惜下血本招
博士、硕士入职就给精装房!又有医院不惜下血本招  历时7年之久,温医生宣判无罪!
历时7年之久,温医生宣判无罪!  重磅!四川发文:严禁限制医生多点执业
重磅!四川发文:严禁限制医生多点执业  与真人医生诊断一致性达96%:AI医生应用前景广阔
与真人医生诊断一致性达96%:AI医生应用前景广阔